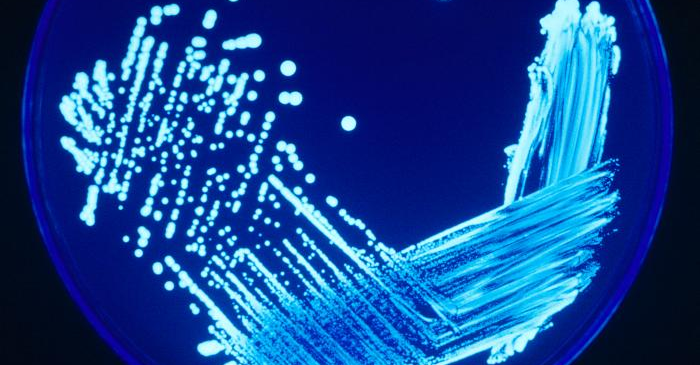

The Clean Energy Revolution podcast
In season 3 of The Clean Energy Revolution podcast, we continue to uncover the big stories in clean energy and the role it plays in tackling the negative effects of climate change.
We’ll take a look at the challenges and opportunities that come with renewable energy, including the impact on people and communities, how to make sure everyone benefits from the clean energy transition and what businesses can do – and are doing – to lead the way.
From AI to infrastructure, wind power to climate policy, expect conversations with experts, industry leaders and passionate individuals who are working towards a greener future.
Join us to discover how our lives will be powered as we work towards a net zero future that doesn't contribute to global warming, and how the industry as a whole can work together to help make this happen for the good of our planet.
Listen to season 3, episode 10:
AI and energy: the new power couple?
There’s an ongoing struggle for balance between the usefulness of AI and its energy demands. Generative AI and large language models are highly energy-intensive, with ChatGPT consuming up to 10 times more electricity than a standard Google search, and the energy consumption of data centres projected to double by 2026. But at the same time, AI has the potential to significantly improve energy efficiency.
In this episode, Laura speaks with Ben Sigrin, Senior Product Manager at GridBeyond, about how the company uses AI to manage energy behind-the-meter (on the consumer side), optimising energy use in buildings and reducing carbon emissions.
AI is also transforming sectors like transportation and agriculture by enhancing overall energy efficiency. Digital twins - virtual models that replicate real-world conditions—could eliminate 5-10% of global greenhouse gas emissions by 2030.
NVIDIA, known for being maker of the graphic processors that are used to train AI, has built its own version of these digital twin models. Director of Product Marketing Shar Narasimhan talks to Carolyn about Earth2, a mammoth digital replica of Earth used to model the extreme weather and climate change that affect our energy networks, and about how AI energy demands are being addressed in the industry.

U.S. News Worsening floods and deterioration pose threats to US dam safety
By MICHAEL PHILLIS and JOHN HANNA
Updated 8:13 PM GMT+5, July 3, 2024
ST. LOUIS (AP) — Early last week, floodwater in rural Minnesota pushed debris against a more than century-old dam and then carved a path around it, eroding so much of the riverbank that most of a house fell into the river. Several days later, intense rain damaged a dam that holds drinking water for Houston, forcing officials to issue a potential failure warning.
“Something like this could happen, and it has happened, all over the country,” said Del Shannon, former president of the U.S. Society on Dams.
There are roughly 90,000 significant dams in the U.S. At least 4,000 are in poor or unsatisfactory condition and could kill people or only harm the environment if they failed, according to data from the U.S. Army Corps of Engineers. They need inspections, upgrades and even emergency repairs.
It’s a difficult problem in part because dams in the U.S. are roughly 60 years old, on average. It requires costly maintenance to keep decades of wear and tear from degrading dams, and resources to fix problems are often scarce, Shannon said.
Advertisement
Blue Earth County owns the Rapidan dam, a 1910 hydroelectric dam in Minnesota that is still standing but was badly damaged last week by the second-worst flood in its history. The dam hasn’t been producing power, as previous floods knocked out that small source of revenue. The county of roughly 70,000 people had been considering spending $15 million on repairs or removing the dam at a cost of $82 million.
“The dollar amounts we’re talking about … are big amounts for a county our size,” said County Administrator Bob Meyer.
A federal inspection in May didn’t find major problems at the Rapidan dam, which isn’t considered to pose a major threat to people if it fully fails. A federal investigation is now expected. Debris clogged the dam during flooding, forcing the river to divert around it — the damage likely wasn’t related to the dam’s repair needs, Meyer said.
In Colorado, officials consider whether a dam is a threat to humans and the severity of its defects. That helps them prioritize scrutiny and funding.
If an owner won’t make needed upgrades, officials can wield a “regulatory hammer” and force owners to store less water behind their dams, reducing pressure and ensuring safety. That can kickstart action — less water in a reservoir can hurt the ability of dam owners to supply water to the communities they serve, for example, according to John Hunyadi who oversees dam safety in Colorado.
But in many states, officials can’t order the worst owners to remove their dams, France said.
“All the state agencies ought to have that authority,” he said, adding that if an owner refuses, the state should be able to do it themselves.
___
Hanna reported from Topeka, Kansas.
___
The Associated Press receives support from the Walton Family Foundation for coverage of water and environmental policy. The AP is solely responsible for all content. For all of AP’s environmental coverage, visit https://apnews.com/hub/climate-and-environment

Millions of people across the US use well water, but very few test it often enough to make sure it's safe
About 23 million U.S. households depend on private wells as their primary drinking water source. These homeowners are entirely responsible for ensuring that the water from their wells is safe for human consumption.
Multiple studies show that, at best, half of private well owners are testing with any frequency, and very few households test once or more yearly, as public health officials recommend. Even in Iowa, which has some of the strongest state-level policies for protecting private well users, state funds for free private water quality testing regularly go unspent.
Is the water these households are drinking safe? There's not much systematic evidence, but the risks may be large.
Nitrate risks
We focused on nitrate, one of the main well water pollutants in rural areas. Major sources include chemical fertilizers, animal waste and human sewage.
Discover the latest in science, tech, and space with over 100,000 subscribers who rely on Phys.org for daily insights. Sign up for our free newsletter and get updates on breakthroughs, innovations, and research that matter—daily or weekly.
Drinking water that contains nitrate can harm human health. Using contaminated water to prepare infant formula can cause "blue baby syndrome," a condition in which infants' hands and lips turn bluish because nitrate interferes with oxygen transport in the babies' blood. Severe cases can cause lethargy, seizures and even death. The EPA limits nitrate levels in public water systems to 10 milligrams per liter to prevent this effect.
Studies have also found that for people of all ages, drinking water with low nitrate concentrations over long periods of time is strongly associated with chronic health diseases, including colorectal cancer and thyroid disease, as well as neural tube defects in developing fetuses.

EPA lead ruling unlikely to resolve water contamination issues in LA public housing
Days after the administrator of the U.S. Environmental Protection Agency visited a Los Angeles public housing project with lead-contaminated water, the agency ordered drinking water systems nationwide to replace every lead pipe within 10 years.
"We've known for decades that lead exposure has serious long-term impacts for children's health. And yet, millions of lead service lines are still delivering drinking water to homes," EPA Director Michael Regan said.
But in Los Angeles—where the discovery of contaminated water in public housing in Watts has shocked officials—the EPA mandate is unlikely to result in immediate change.
When Regan joined Mayor Karen Bass on a visit to the 700-unit Jordan Downs complex this month, he suggested the brain-damaging element could be from household plumbing—a critical risk in older homes.
It's a possibility that highlights the difficulty of eliminating the threat of lead in California drinking water.
While the new EPA rule targets lead service lines connecting homes to water mains, it doesn't address plumbing inside the building that can still pose a risk, such as lead soldering, brass fixtures and interior mains.
"If you can outlaw lead in fuel, for God's sake, why can't we outlaw lead in drinking water?" asked Timothy Watkins, president of the Watts Labor Community Action Committee. "And in all plumbing components, faucets, valves, pipes—you name it."
Although the installation of lead service lines was banned in 1986, around 9 million homes nationwide still receive tap water through these aging pipelines, according to EPA estimates. Over time, as these pipes have corroded, they have leached lead—a chemical with no safe level of exposure—into tap water. When ingested by children, the heavy metal can cause irreversible brain damage and behavioral issues.
The Natural Resources Defense Council has long advocated for addressing widespread problems of lead-contaminated drinking water. The environmental group has called for more testing and replacement of lead pipes. It has also criticized California officials for not taking advantage of federal funds available under the Bipartisan Infrastructure Law to pay for the removal of lead from drinking water systems.

Researchers connect declining atmospheric sulfur dioxide levels to rise in Legionnaires' disease
Declining atmospheric sulfur dioxide levels might be related to the global rise in Legionnaires' disease—a severe form of pneumonia caused by inhaling the pathogenic bacteria Legionella. So reports a new University at Albany study, published today in the journal PNAS Nexus, which examined trends in atmospheric sulfur dioxide, Legionnaires' disease incidence, and the role of cooling towers in harboring Legionella.
Sources of Legionella—which can multiply in building water systems and spread through the air—are well known, as are seasonal trends that affect the bacteria as a public health risk. Yet, the global increase in cases has been a puzzle.
According to the U.S. Centers for Disease Control and Prevention (CDC), from 2000 to 2018, Legionnaires' disease cases have seen a nine-fold increase nationally, with New York State carrying the highest disease burden and having the fastest increase in the country.
"Atmospheric acidity influences the survival time of Legionella," said co-lead author Fangqun Yu, senior research faculty at UAlbany's Atmospheric Sciences Research Center. "This is true of Legionella found in contaminated droplets from cooling towers and other sources such as hot tubs and decorative fountains. Here, we examined the transmission pathway of Legionella into the air. Understanding how changing environmental conditions influence Legionella proliferation is critical to mitigating this important public health risk."
Environmental impact on Legionella bacteria and disease risk
Legionella are highly sensitive to acidity and perish quickly in low-pH conditions. Over the past half-century, thanks to legislation designed to cut sulfur dioxide emissions, pH levels in the atmosphere have increased, with major benefits for human and environmental health. With less sulfur dioxide in the atmosphere, however, water droplets emitted from cooling towers and other water systems are less acidic, making it easier for resident Legionella to survive, become airborne and remain viable as they spread.
The UAlbany researchers focused on cooling towers—water handling systems associated with industrial, commercial and large residential HVAC systems. Among the many places Legionella flourish (e.g., hot water tanks, showerheads, sink faucets), cooling towers are a leading concern because they can emit plumes of airborne bacteria, which, when conditions are right, can drift and infect people as far as 10km away.
InfraTerra Latest News
Stay informed with the latest updates from InfraTerra, your trusted source for developments in earth sciences, infrastructure, and the built environment. Our news section highlights groundbreaking projects, innovative technologies, and industry insights shaping the future of sustainable development.
